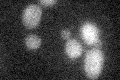
YER143W
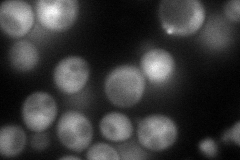
YER143W
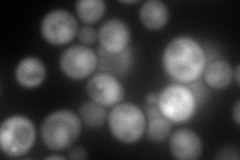
YER143W
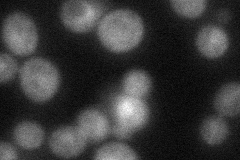
YER143W
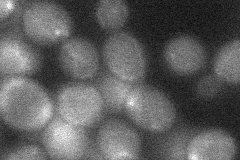
YER143W
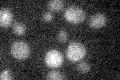
YER143W

View description
DNA damage-inducible v-SNARE binding protein, contains a ubiquitin-associated (UBA) domain, may act as a negative regulator of constitutive exocytosis, may play a role in S-phase checkpoint control
Localization:
Intensity:
Fold change:
Significance:
-
C’ GFP library in SD
below threshold14.64 -
N' NOP1pr-GFP in SD
cytosol,nucleus108.156 -
N' TEF2pr-mCherry in SD
cytosol160.953 -
N' NATIVEpr-GFP in SD
cytosol47.5058 -
N' TEF2pr-VC and Cyto-VN in SD
below threshold24.876 -
C’ GFP library in SD+DTT

cytosol14.711No -
C’ GFP library in SD+H2O2

cytosol16.021.09No -
C’ GFP library in Starvation Media
cytosol15.551.06No -
C’ GFP library on the background of Pup2-DaMP

below threshold -
C’ GFP library on the background of CCT mutant

below threshold14.87891.01529No
